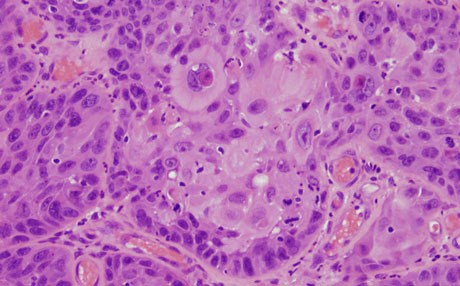

رووداو-زە سەن
گۆڕانكاری نائاسایی لە ئەندامە سێكسییەكانی جەستە، رەنگ نیگەرانت بكات لەبارەی ئەو هەوكردنانەی لەڕێگەی سێكس دەگوێزرێنەوە، بەڵام هەندێكجار لەوەش خراپترن و نیشانەی هەبوونی شێرپەنجەن!
ئەمانە هەندێك نیشانەن، كە ئەگەر هەبن، پێویستدەكات راوێژ بە پزیشك بكەی سەبارەت بە هەبوونی شێرپەنجەی چووك:
1-برینێك لە چووك كە دوای 4 هەفتە ساڕێژ نەبێ. برینەكە رەنگە شێوەی جیاوازبێ هەر لە تلۆق و برینی تەڕەوە تاكو شێوە بالووكە
2-خوێنلێهاتن، بەتایبەت لەژێر پێستی كۆتایی چووك
3-دەردراوێكی بۆن ناخۆش
4-گێڕانەوەی پێستی كۆتایی چووك بە ئاستەم
5-پەیدابوونی پەڵەیەكی نوێ
6-گۆڕانی رەنگی چووك یان پێستی كۆتاییەكەی
7-پەیدابوونی گرێ لە بنڕان
8-هەست بە ماندوویی كردن
9-سكئێشەی درێژخایەن
10-ئازاری بەربڵاوی ئێسك
11-دابەزینی بێ مەبەستی كێش

کۆمێنتەکان
وەک میوان کۆمێنتێك بنووسە یان وەرە ژوورەوە و ههموو خزمەتگوزارییەکان بهكاربێنه
کۆمێنتێک دابنێ